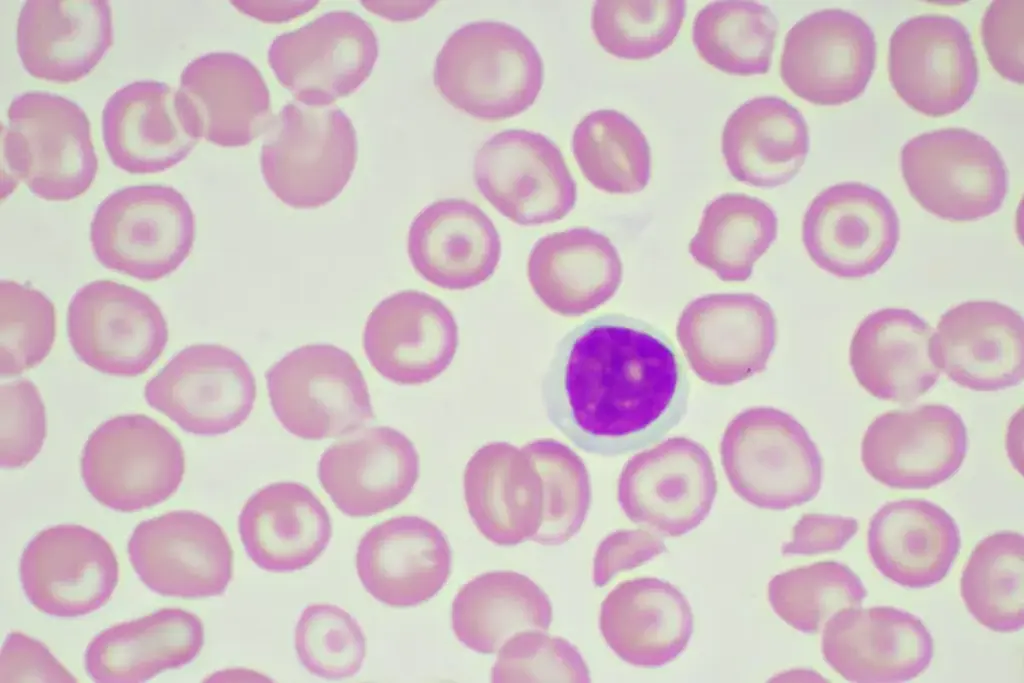
Hemophilia Cure Search: Amazing Modern Breakthroughs 3 Hemophilia Cure Search: Amazing Modern Breakthroughs

Hemophilia is a rare genetic disorder that makes blood hard to clot. It was once seen as a lifelong condition. But, groundbreaking advances in gene therapy are changing this view. They offer hope for a cure.
At LIV Hospital, we focus on top-notch healthcare for international patients. Our team keeps up with the latest in medical science. This includes gene therapy for bleeding disorders.
Key Takeaways
- Gene therapy is emerging as a promising treatment for hemophilia.
- Advances in medical technology are improving the quality of life for patients with bleeding disorders.
- A functional cure for hemophilia may become a reality with ongoing research.
- LIV Hospital is dedicated to providing cutting-edge care for international patients.
- Comprehensive support services are available for patients seeking treatment abroad.
Understanding Hemophilia: A Blood Clotting Disorder
Hemophilia is a rare genetic disorder that makes it hard for the body to stop bleeding. It’s caused by a lack of proper blood clotting. We’ll look into how hemophilia works, its effects, and its genetic roots.
What Is Hemophilia and How Does It Affect the Body?
Hemophilia mainly affects the blood’s clotting factors. Factor VIII and Factor IX are key proteins for blood to clot. Without enough of these, the blood can’t clot well, leading to prolonged bleeding.
The symptoms of hemophilia vary. They include frequent bruising, joint pain from bleeding, and sometimes spontaneous bleeding. Knowing these symptoms is key for diagnosis and treatment.
The Genetic Basis of Hemophilia
Hemophilia is inherited, meaning it comes from parents. The genes for hemophilia are on the X chromosome. This is why it mostly affects males. Females can carry the mutated gene but usually don’t show symptoms. They can pass it to their children, though.
The genetic mutation messes with the clotting factors. Genetic testing can find carriers and those with the disorder. This helps in managing the condition early on.
Types of Hemophilia and Their Severity Levels

Hemophilia is complex, with different types and severity levels. This affects how patients are treated. There are mainly three types: Hemophilia A, B, and C. Each is caused by a lack of a specific clotting factor.
Hemophilia A: Factor VIII Deficiency
Hemophilia A, or classic hemophilia, is due to a lack of factor VIII. This protein is key for blood to clot. People with Hemophilia A bleed a lot, even from small injuries. The severity depends on how much factor VIII is in the blood.
Severity levels of Hemophilia A are based on factor VIII activity:
- Mild: 5-40% of normal factor VIII activity
- Moderate: 1-5% of normal factor VIII activity
- Severe:
Hemophilia B: Factor IX Deficiency
Hemophilia B, or Christmas disease, is caused by a lack of factor IX. Like Hemophilia A, its severity is based on factor IX activity. Patients have bleeding episodes similar to those with Hemophilia A. Treatment often involves replacing factor IX.
The severity levels of Hemophilia B are based on factor IX activity:
- Mild: 5-40% of normal factor IX activity
- Moderate: 1-5% of normal factor IX activity
- Severe:
Hemophilia C and Other Rare Forms
Hemophilia C is rare and caused by a lack of factor XI. It’s different because it can affect both males and females. It often has mild symptoms.
Other rare forms include deficiencies in factors II, V, VII, X, or XIII. These are very rare and can present differently.
Knowing about the different types and severity levels of hemophilia is key. Healthcare providers need this knowledge to create effective treatment plans for each patient.
The Global Impact of Hemophilia
Hemophilia affects over 1.1 million people worldwide, making it a big health challenge globally. It makes blood unable to clot, leading to long bleeding. This condition impacts not just those who have it but also their families and healthcare systems.
Prevalence and Demographics
Hemophilia is found in about 1 in 10,000 people worldwide. The World Federation of Hemophilia says there are over 400,000 with hemophilia A and 100,000 with hemophilia B. It mostly affects males because it’s inherited in a certain way.
Let’s look at the demographics of hemophilia in different areas:
|
Region |
Estimated Hemophilia A Cases |
Estimated Hemophilia B Cases |
|---|---|---|
|
North America |
70,000 – 80,000 |
15,000 – 20,000 |
|
Europe |
100,000 – 120,000 |
20,000 – 25,000 |
|
Asia |
200,000 – 250,000 |
40,000 – 50,000 |
|
Latin America |
30,000 – 40,000 |
6,000 – 8,000 |
The Challenge of Undiagnosed Cases
Even with many diagnosed cases, finding undiagnosed ones is a big challenge. In many places, people lack access to the right tests and care. It’s thought that up to 75% of people with hemophilia worldwide don’t get diagnosed or treated well.
“The lack of access to diagnosis and treatment for hemophilia is a significant issue in many parts of the world. We need to work together to improve awareness, diagnosis, and care for individuals affected by this condition.” –
A spokesperson for the World Federation of Hemophilia
Work is being done to help diagnose and treat more people. This includes training for healthcare workers and setting up treatment centers in areas that need them. By tackling undiagnosed cases, we aim to give full care to everyone with hemophilia.
Traditional Management of Hemophilia
Hemophilia treatments have evolved significantly due to factor replacement therapy. This has greatly improved how patients live with the condition. It has made managing hemophilia easier and improved their quality of life.
Factor Replacement Therapy: The Standard of Care
Factor replacement therapy adds the missing clotting factor for patients with hemophilia. It uses either plasma-derived or recombinant clotting factors. Recombinant factors are more common now because they are safer and easier to get.
Benefits of Factor Replacement Therapy:
- Reduces the frequency of bleeding episodes
- Improves joint health and mobility
- Enhances overall quality of life
A leading hematologist says, “Factor replacement therapy has changed many hemophilia patients’ lives. It lets them live more active and normal lives.”
“The introduction of recombinant clotting factors has been a game-changer in hemophilia care, providing a safer and more reliable treatment option.”
On-Demand vs. Prophylactic Treatment Approaches
There are two main ways to use factor replacement therapy: on-demand and prophylactic. On-demand treatment is given when a patient bleeds. Prophylactic treatment is regular infusions to prevent bleeding.
|
Treatment Approach |
Description |
Benefits |
|---|---|---|
|
On-Demand |
Treatment given at the time of bleeding |
Immediate relief from bleeding episodes |
|
Prophylactic |
Regular infusions to prevent bleeding |
Reduces frequency of bleeding episodes, improves joint health |
Prophylactic treatment is often suggested for those with severe hemophilia. It can greatly lower the risk of joint damage and other bleeding-related problems.
Choosing between on-demand and prophylactic treatment involves several important factors. These include the severity of hemophilia, patient lifestyle, and personal preferences.
Living with Hemophilia: Patient Experiences
Living with hemophilia presents a complex interplay of medical, social, and mental health challenges. People with hemophilia face special challenges that affect their daily lives and happiness.
Quality of Life Considerations
Dealing with hemophilia means more than just medical treatment. It’s about improving overall life quality. Quality of life considerations include being able to move freely, work, and socialize without worrying about bleeding.
Mason Gentry-Brown’s story shows the big role of psychosocial aspects in managing serious health issues. His story stresses the need for a supportive care system that meets both physical and emotional needs.
“Living with a chronic condition like hemophilia requires resilience, support, and access to complete care. It’s not just about managing bleeds; it’s about living a full life.”
Psychosocial Aspects of Managing a Chronic Condition
The psychosocial aspects of hemophilia care are key, as it can impact mental health and social life. Anxiety, depression, and feeling alone can come from the chronic nature of the condition and the ongoing need for management.
Managing hemophilia well means more than just treatment. It also means addressing these psychosocial needs. This includes counseling, support groups, and educational programs to help patients cope better and improve their quality of life.
- Access to mental health services
- Support from family and community
- Education on managing hemophilia
- Participation in hemophilia camps and support groups
By focusing on the whole person in hemophilia care, we can make life better for those with this chronic condition. It’s about building a supportive environment that helps with both physical and mental health.
The Evolution of Hemophilia Treatments
Hemophilia treatments have changed a lot over time. This change is thanks to new medical technology and a better understanding of the disease. We’ve moved from simple care to advanced therapies today.
Historical Perspective on Hemophilia Care
Older treatments for hemophilia mainly focused on symptom management. Factor replacement therapy came along and changed everything. It directly tackled the root cause of hemophilia.
At first, factor replacement therapy had its hurdles. It needed frequent doses and sometimes caused inhibitors. But these problems led to more research and better treatments.
Milestones in Treatment Development
There have been key moments in hemophilia treatment’s evolution. The introduction of recombinant factor products was a big leap. It made treatments safer and less dependent on plasma.
- Development of more purified factor concentrates
- Introduction of recombinant factor VIII and IX products
- Advances in prophylactic treatment regimens
Extended Half-Life Products
The newest breakthrough is extended half-life (EHL) products. These stay in the blood longer. This means patients need fewer infusions to keep factor levels up.
|
Product Type |
Half-Life Extension |
Infusion Frequency |
|---|---|---|
|
Standard Factor VIII |
Baseline |
Every 2-3 days |
|
EHL Factor VIII |
1.4-1.6 times longer |
Every 4-7 days |
|
EHL Factor IX |
3-5 times longer |
Every 1-2 weeks |
EHL products are a big step forward in hemophilia care. They offer patients more flexibility and could make sticking to treatment easier.
Current Innovative Therapies for Hemophilia
New treatments are changing how we manage hemophilia, bringing hope to patients everywhere. These changes come from advances in medical science and technology.
Non-Factor Replacement Options
Non-factor replacement therapies are a new area in hemophilia treatment. They help the body clot naturally, not just replace clotting factors. This could make treatment easier and better for patients.
These therapies might work longer, needing less frequent doses. This could help patients stick to their treatment plans, improving their lives.
Monoclonal Antibody Treatments
Monoclonal antibodies are showing promise in treating hemophilia. They target proteins in clotting, helping the body form clots better. This can reduce bleeding episodes.
Monoclonal antibodies offer several benefits. They might need less frequent doses and could lower the risk of inhibitors. This makes them a good choice for long-term treatment.
Subcutaneous Treatment Delivery Methods
Subcutaneous delivery is becoming a popular way to give hemophilia treatments. It involves injecting under the skin, not into a vein. This makes it easier and less scary for patients.
Subcutaneous treatments could make life easier for patients. They make treatment simpler, helping patients live more normally despite their condition.
We’re excited about these new therapies for hemophilia. With ongoing research, we hope to make life even better for patients. New treatments will be key in improving hemophilia care.
Gene Therapy: The Frontier of Hemophilia Treatment
Gene therapy is a new hope for hemophilia patients around the world. It involves putting a healthy gene into a patient’s cells to fix the genetic problem. This method could change how we treat hemophilia.
How Gene Therapy Works for Hemophilia
Gene therapy delivers a working gene into a patient’s cells. This is done using viral vectors that are safe and carry the gene. Once inside, the gene makes the clotting factor needed to stop bleeding.
Breakthrough 13-Year Studies in Hemophilia B Patients
Studies on gene therapy for hemophilia B have shown great promise. A 13-year study found it works well over time. Patients had fewer bleeding episodes.
Long-Term Results: Tenfold Reduction in Annual Bleeding Rates
The results of these studies are very encouraging. They show a tenfold reduction in annual bleeding rates for hemophilia B patients. This means less pain and fewer bleeding episodes for these patients.
A recent clinical trial found that gene therapy could cure hemophilia B. It keeps factor IX levels high for a long time.
“The reduction in annual bleeding rates we’ve observed is a testament to the transformative power of gene therapy,” saidthe study’s lead researcher.
|
Treatment Approach |
Annual Bleeding Rate Reduction |
Quality of Life Improvement |
|---|---|---|
|
Gene Therapy |
Tenfold reduction |
Significant |
|
Factor Replacement Therapy |
Variable |
Moderate |
Is Gene Therapy a “Functional Cure” for Hemophilia?
Gene therapy is being looked at as a possible “functional cure” for hemophilia. It aims to fix the root cause of the disease by helping the body make the missing clotting factor. Early results from clinical trials are encouraging, giving hope to those with this chronic condition.
Defining “Cure” in the Context of Hemophilia
The word “cure” can mean different things when talking about hemophilia. A traditional cure means getting rid of the disease completely. But with gene therapy, a “functional cure” means the treatment works well, making it less necessary to keep getting factor replacement therapy.
A study in the New England Journal of Medicine found that gene therapy keeps factor levels normal for a long time. This is a big step toward a “functional cure,” as it cuts down on bleeding and improves life quality for patients.
“Gene therapy has the power to change how we treat hemophilia, giving a chance for a cure that could greatly improve patient outcomes.”
Benefits and Limitations of Current Gene Therapies
Today’s gene therapies for hemophilia have many good points. They help keep the clotting factor levels up and reduce bleeding. But, there are downsides like the chance of an immune reaction and the high cost of treatment.
|
Benefits |
Limitations |
|---|---|
|
Sustained factor production |
Potential for immune responses |
|
Reduced bleeding episodes |
High treatment cost |
|
Improved quality of life |
Limited long-term data |
Patient Selection for Gene Therapy
Choosing the right patients for gene therapy is key. Those with severe hemophilia, no inhibitors, and good health are usually considered. The selection process includes genetic tests and liver function checks.
The World Federation of Hemophilia says picking the right patients is vital for safe and effective gene therapy. They look at how severe the hemophilia is, if there are inhibitors, and the patient’s overall health.
Gene therapy is changing how we treat hemophilia. It’s not a traditional cure, but it’s a hopeful step toward a “functional cure.” It’s making a big difference in the lives of patients around the world.
Challenges and Considerations in Hemophilia Treatment
The journey to manage hemophilia is filled with challenges. Despite new treatments, patients and doctors face big hurdles.
Access to Care and Treatment Costs
Access to care is a big issue in managing hemophilia. Many patients face high treatment costs. This includes the cost of clotting factor concentrates and other therapies.
“The high cost of hemophilia treatment can be a significant burden for patients and their families,” say healthcare professionals. This financial strain can limit access to necessary care. It can also affect overall health outcomes.
Inhibitor Development and Management
Inhibitor development is a major concern in hemophilia care. Managing inhibitors needs special treatment approaches. This includes immune tolerance induction and the use of bypassing agents.
Managing inhibitors involves a detailed strategy. This includes:
- Regular monitoring for inhibitor development
- Tailored treatment plans to manage bleeding episodes
- Immune tolerance induction therapy to eliminate inhibitors
The Economics of Hemophilia Research and Treatment
The global hemophilia market is set for big growth. This is thanks to new treatments and more money for research. The field of hemophilia care is changing fast, and so is the economy.
Market Projections: $15.29 Billion to $27.27 Billion by 2034
The hemophilia market is expected to grow from $15.29 billion to $27.27 billion by 2034. This growth comes from new therapies and more people using preventive treatments. For more details, check out.
More people are getting diagnosed and learning about hemophilia. This means more patients are looking for treatment. So, the demand for hemophilia care products is going up.
Investment in Research and Development
Big investments in research and development are helping the hemophilia market grow. Companies and research groups are working on new treatments. These include gene therapy and extended half-life products.
These efforts are making life better for people with hemophilia. They’re also making care more efficient. As research gets better, we’ll see even more new treatments.
There’s also a push to make treatments that need fewer infusions. This will make life easier and better for patients.
Advanced Care Options for Hemophilia Patients
Advanced care for hemophilia has evolved. It’s not just about managing symptoms anymore. Now, it’s about giving patients a full range of support. This includes new treatments and care options that greatly improve their lives.
Specialized Treatment Centers
Specialized treatment centers are changing the game for hemophilia treatment. They offer hope for a brighter future. These centers have top-notch facilities and teams of experts in hemophilia care.
- Comprehensive care teams that include hematologists, nurses, physiotherapists, and counselors.
- Access to the latest treatments, including gene therapy and novel factor replacement therapies.
- Patient education programs to empower individuals with hemophilia to manage their condition effectively.
LIV Hospital’s Approach to Hemophilia Care
At LIV Hospital, we’re all about leading-edge, ethical care for hemophilia patients. Our focus is on personalized, all-encompassing care that meets each patient’s unique needs.
Our key strengths include:
- A multidisciplinary team of experts who collaborate to develop tailored treatment plans.
- State-of-the-art facilities that enable us to deliver cutting-edge treatments.
- A patient-centric approach that prioritizes quality of life and patient satisfaction.
“The care I received at LIV Hospital has been life-changing. The team’s dedication and expertise have given me the confidence to manage my hemophilia effectively.” – A LIV Hospital patient
LIV Hospital is leading the way in hemophilia treatment. We combine advanced care with a focus on compassionate, patient-centered care. We believe every patient deserves the best care, and we’re committed to making that happen.
Conclusion: The Evolving Landscape of Hemophilia Care
Hemophilia care is changing fast, thanks to new gene therapy and treatments. We’ve made big strides in understanding hemophilia and its causes. Now, patients have many effective treatments to live better lives.
The future looks bright for hemophilia care. Research and development keep going, aiming to make treatments even better. Gene therapy is a big hope for lasting, effective care. We’re excited to see how care will improve for patients.
Specialized treatment centers like LIV Hospital are leading the way. They offer top-notch care to patients from around the world. Working together, healthcare providers, researchers, and patients will shape the future of hemophilia care.
FAQ
What is hemophilia and how does it affect the body?
Hemophilia is a rare genetic disorder. It makes it hard for the body to form blood clots. This leads to prolonged bleeding.
It’s caused by a lack of either factor VIII (hemophilia A) or factor IX (hemophilia B). These proteins are key for blood clotting.
What are the different types of hemophilia?
There are mainly three types of hemophilia. Hemophilia A is due to a lack of factor VIII. Hemophilia B is caused by a lack of factor IX.Hemophilia C is milder. It’s caused by a lack of factor XI.
How is hemophilia traditionally managed?
Traditionally, hemophilia is managed with factor replacement therapy. This therapy replaces the missing clotting can be used on-demand to treat bleeding or regularly to prevent it.
What is gene therapy and how does it work for hemophilia?
Gene therapy is a new treatment. It introduces a healthy gene into the patient’s cells. This makes the body produce the missing clotting reduces or eliminates the need for factor replacement therapy.
Can gene therapy be considered a “functional cure” for hemophilia?
Gene therapy has shown great promise in clinical trials. Some patients have seen a big drop in bleeding not a traditional cure, it can be seen as a “functional cure.” It helps restore normal blood clotting and improves life quality.
What are the challenges and considerations in hemophilia treatment?
Treating hemophilia comes with challenges. These include access to care, high treatment costs, and the risk of are antibodies that can block the effect of factor replacement therapy. This makes treatment harder.
What is the role of specialized treatment centers in hemophilia care?
Specialized centers, like LIV Hospital, are key in hemophilia care. They offer advanced treatments, including gene also provide support from different disciplines. This helps manage the condition and improve life quality.
What is the current state of research and development in hemophilia treatment?
Research in hemophilia treatment is ongoing. It focuses on new therapies, like gene therapy, and non-factor replacementantibody treatments are also being explored. This research is driven by investment and aims to improve care.
How does hemophilia affect quality of life?
Hemophilia can greatly affect life quality. It causes physical limitations, emotional distress, and social management and treatment can improve life quality. This allows patients to live active and fulfilling lives.
What are the economic implications of hemophilia treatment?
Treating hemophilia can be expensive. Factor replacement therapy is a big therapy, though costly upfront, may save money in the long run. It reduces the need for ongoing factor replacement therapy.
References
National Institutes of Health (NIH) – PMC. Hemophilia and Quality of Life. https://pmc.ncbi.nlm.nih.gov/articles/PMC11849425/
National Heart, Lung, and Blood Institute (NHLBI). Hemophilia. https://www.nhlbi.nih.gov/health/hemophilia


































